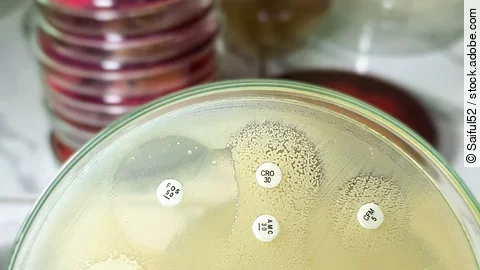

Stockholm (dpa) – Hepatitis, HIV, Tuberkulose (TB) und sexuell übertragbare Infektionen wie Syphilis und Gonorrhoe stellen weiterhin große Herausforderungen für die Gesundheitssysteme in Europa dar. Das ist eine der Hauptaussagen eines neuen Berichtes des Europäischen Zentrums für die Prävention und die Kontrolle von Krankheiten (ECDC).
Obwohl diese Krankheiten vermeidbar seien, führten sie demnach zu zahlreichen Krankheitsfällen und zu jährlich fast 57.000 Todesfällen in der Europäischen Union (EU) und im Europäischen Wirtschaftsraum (EWR).
Europäische Länder laufen Gefahr, Ziele zu verfehlen
Als eines der 17 Ziele für nachhaltige Entwicklung streben die Vereinten Nationen (UN) bis 2030 «ein gesundes Leben für alle Menschen» an – und als Unterziele auch die Bekämpfung der Virushepatitis sowie die Beseitigung der Aids- und TB-Epidemien. Die EU-Gesundheitsbehörde mit Sitz in Stockholm hat nun untersucht, inwiefern die europäischen Länder ihre bis 2025 gesteckten Teilziele auf dem Weg dorthin erreicht haben.
Der neue ECDC-Bericht zeigt: Die meisten Länder laufen entweder Gefahr, die Ziele bis 2030 nicht zu erreichen oder sie verfügen nicht über ausreichende Daten, um ihren Fortschritt zu messen. ECDC-Direktorin Pamela Rendi-Wagner sagte: «Diese Krankheiten sind vermeidbar, ebenso wie die Belastungen, die sie für das Gesundheitswesen, die Patienten und ihre Familien darstellen. Wir haben 5 Jahre, um zu handeln; wir müssen sie nutzen.»
Zahl der gemeldeten Gonorrhoe-Fälle die höchste seit 2009
Die geschätzte Inzidenz von HIV und Tuberkulose ist laut ECDC-Bericht im Untersuchungszeitraum zwar zurückgegangen, liege aber über dem für 2025 angestrebten Wert. Für Virushepatitisden und sexuell übertragbare Infektionen gebe es keine Inzidenz-Zahlen, jedoch sei die Zahl der Diagnosen von Gonorrhoe, Syphilis und akuter Hepatitis B in vielen EU- und EWR-Ländern gestiegen. Am stärksten war demnach der Anstieg an neu gemeldeten Gonorrhoe-Fällen – ihre Anzahl sei die höchste seit 2009.
Im Bereich der Vorbeugung der Krankheiten seien zwar Fortschritte erzielt worden, doch auch hier seien die Zielvorgaben für 2025 laut ECDC verfehlt worden. Zu den besonders effektiven Präventionsmaßnahmen zählen der Gebrauch von Kondomen, Programme, die den Tausch alter Spritzen gegen neue ermöglichen, Hepatitis-B-Impfungen sowie die sogenannte Präexpositionsprophylaxe (PrEP), die Menschen mit erhöhtem Infektionsrisiko vor einer HIV-Ansteckung schützen soll.